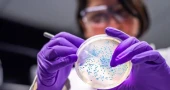
The bacteria turning plastic waste into painkillers

Science-&-Innovation
Turbine dispute threatens major US offshore wind project
The developer of a large offshore wind project in Massachusetts has filed a lawsuit against its turbine supplier to prevent it from withdrawing from the project.
Vineyard Wind initiated legal action against GE Renewables after its parent company, GE Vernova, announced plans to end its turbine service and maintenance contracts by the end of April.
GE Vernova claims Vineyard Wind owes about $300 million for completed work. However, Vineyard Wind argues that the company is instead responsible for roughly $545 million in damages linked to a major turbine blade failure in July 2024 and the resulting delays.
During that incident, fragments from a broken blade washed ashore on Nantucket beaches at the height of the tourist season, causing disruption to local businesses. GE Vernova later agreed to pay $10.5 million in compensation to affected businesses.
In its lawsuit, Vineyard Wind accuses GE Renewables of poor performance and warns that allowing the company to exit the project now would cause serious and lasting harm. A company spokesperson said the legal action aims to ensure GE fulfills its responsibilities to both the project and the region, which is expected to deliver significant economic benefits and long-term savings for electricity customers.
GE Vernova, however, maintains it has the right to terminate the agreement due to nonpayment and said it will defend its position in court while continuing to prioritize safety and contractual obligations.
Although construction of Vineyard Wind was completed in March and the project has already been supplying electricity to the grid, full operations are expected soon. The lawsuit notes that GE Renewables is uniquely qualified to complete the remaining work, making it difficult to find a replacement.
The blade failure was attributed by GE Vernova to a manufacturing issue at a Canadian facility rather than a design flaw. Following the incident, most of the installed blades were replaced, delaying the project by nearly two years.
The project has also faced political scrutiny, particularly from the Trump administration, which temporarily halted several offshore wind projects over national security concerns before courts allowed construction to resume.
Located off the coast of Massachusetts, Vineyard Wind is a joint venture between Avangrid and Copenhagen Infrastructure Partners. With 62 turbines, it is expected to generate enough renewable energy to power around 400,000 homes.
1 month ago
Chinese firm unveils humanoid robot powered by advanced action model
Chinese robotics company Westlake Robotics has introduced its humanoid robot, Titan o1, driven by a self-developed large-scale model known as General Action Expert (GAE), capable of replicating human movements in real time without constraints of time or space.
The company said the model allows multiple robots to carry out identical tasks simultaneously under the control of a single operator.
During a demonstration in Hangzhou, an operator wearing a motion-capture suit performed actions such as waving, turning and kicking a ball, while Titan o1 mirrored each movement within milliseconds.
The robot’s motions including arm swings, torso rotations, step length and leg lift during the kick remained closely synchronized with the operator’s rhythm.
“These actions were instant responses to the operator’s spontaneous movements,” said Westlake Robotics founder Professor Wang Donglin, adding that Titan o1 can quickly adjust to different operators and variations in movement.
He compared the GAE model to the human cerebellum, which coordinates movement, balance and precision, noting that it enables the robot to execute appropriate actions immediately upon receiving signals, even if the movements have not been performed before.
Westlake Robotics also said the GAE model supports cross-embodiment deployment, meaning it can be applied to various robots with differing designs and sizes.
2 months ago
Service dog Alfred helps secure nationwide rights for disabled lyft riders
Lyft has agreed to a settlement ensuring that blind and other disabled passengers can travel with their service animals nationwide, following a complaint in Minnesota.
College student Tori Andres contacted the Minnesota Department of Human Rights after several Lyft drivers refused to let her guide dog, Alfred, accompany her. The department found that Lyft had violated the state’s Human Rights Act. Under the settlement, Lyft will update its driver training and app features to make the protections apply across the U.S., not just in Minnesota.
"This case is deeply personal because I travel almost everywhere with my guide dog," Andres said at a news conference, with Alfred lying quietly at her feet. "He is my eyes, my freedom, and why I can live independently."
The settlement requires Lyft to educate drivers about passengers’ rights and warns that drivers could be deactivated for violating the law. Drivers are prohibited from refusing rides to passengers who use service animals, wheelchairs, or have low or no vision. Minnesota will monitor Lyft’s compliance for three years, and Andres will receive $63,000 as part of the settlement.
Rebecca Lucero, the state’s Human Rights Commissioner, said, "We expect all riders in Minnesota and across the country will benefit from these changes."
Lyft, however, downplayed the settlement, stating that it had already enforced policies to protect service animal users and that alleged violations were by independent drivers. The company emphasized that discrimination has no place in its platform.
Recent app updates allow riders to notify drivers about service animals and report refusals. Drivers who try to cancel such rides receive an immediate in-app warning that refusing service animals is illegal and could lead to termination.
The settlement was reached without a lawsuit. Although Uber is not part of the agreement, Minnesota’s Human Rights Act applies to all ride-share companies. Lucero urged all businesses to review their policies to ensure compliance.
The federal government is also pursuing a separate lawsuit against Uber over alleged discrimination against disabled riders, including those with service dogs.
"Access to ride shares like Lyft is not a convenience it is a civil right," Lucero said.
2 months ago
NASA postpones crewed moon mission to March after hydrogen leaks
NASA has delayed its much-anticipated crewed mission around the moon until at least March after hydrogen fuel leaks disrupted a key fueling test of its new mega rocket.
The problem surfaced during a full dress rehearsal at Kennedy Space Center, forcing officials to stop the countdown. Similar hydrogen leaks had also delayed the debut of the Space Launch System (SLS) rocket three years ago. Hydrogen, while efficient, is highly flammable and difficult to manage.
“This issue caught us by surprise,” said John Honeycutt, NASA’s SLS program manager, speaking hours after Monday’s test was halted. Before the leaks, NASA had hoped to launch as early as this weekend, marking humanity’s first return to the moon since 1972.
According to NASA, the delay of about a month will give engineers time to run another fueling test before committing the four-member crew three Americans and one Canadian to the lunar flyby mission. It remains unclear when the next rehearsal will take place.
Officials said any damaged seals or parts can likely be fixed at the launch pad. Moving the rocket back to the Vehicle Assembly Building would cause a much longer delay.
The leaks appeared early during the loading of super-cold liquid hydrogen and reappeared later, eventually stopping the countdown at five minutes. Controllers aimed to reach the final 30 seconds, but hydrogen levels rose above safety limits.
NASA teams tried several fixes, including pausing the fuel flow to warm the area and adjusting hydrogen flow rates methods that helped during the uncrewed SLS launch in 2022. This time, however, the leaks persisted.
NASA research plane makes emergency landing in Texas after gear failure
With the launch now pushed to at least March 6, mission commander Reid Wiseman and his crewmates have been cleared to exit quarantine in Houston. They will reenter quarantine two weeks before the next launch attempt. Wiseman said he was proud of the launch team’s work despite the challenges.
NASA officials said cold weather did not cause the leaks. Heaters kept the Orion capsule warm, while protective systems safeguarded the rocket.
Amit Kshatriya, NASA’s associate administrator, reminded reporters that the SLS is still an experimental vehicle and that long gaps between tests add to the challenge.
The nearly 10-day mission will send astronauts around the moon to test life-support and other critical systems. They will not land or enter lunar orbit. The Artemis program ultimately aims to return astronauts to the lunar surface this time near the moon’s south pole—and support longer stays in the years ahead.
3 months ago
AI-powered domestic robots set to enter homes, but human control still key
The dream of having a robot butler handle household chores is inching closer to reality as Silicon Valley prepares to launch the first multi-purpose domestic robots this year. Robots like Eggie, NEO, Isaac, and Memo are being trained to fold laundry, load dishwashers, water plants, and clean, promising to reduce daily household drudgery.
During a recent visit to robot start-ups, BBC reporter Joe Tidy observed Eggie of Tangible AI slowly hanging jackets, stripping beds, and wiping spills, while NEO from 1X watered plants, fetched drinks, and tidied kitchenware. Despite these capabilities, both bots relied heavily on human operators controlling them remotely, a detail often downplayed in promotional videos.
Bipasha Sen, founder of Tangible AI, expressed optimism about the technology’s pace of improvement, saying, “Today people aspire to own a car and a house. In the future, they’ll want a robot too.” Similarly, 1X CEO Bernt Børnich highlighted that NEO combines autonomous action with human assistance, with AI learning from extensive data to navigate complex home environments.
Other start-ups are also pushing the boundaries. Weave Robotics is testing Isaac in laundromats, folding clothes autonomously, while Sunday AI’s Memo robot demonstrated handling fragile items and preparing coffee, albeit slowly. Physical Intelligence, meanwhile, focuses on developing AI software that can give “intelligence” to any robot body, aiming for broader adaptability in households.
Experts note that cost and privacy could limit early adoption, with NEO priced around $20,000 or $500 a month. While domestic robots may initially appeal to wealthy early adopters, engineers remain confident that AI-driven household assistants could become a common sight in homes in the coming decades.
With inputs from BBC
4 months ago
Humanoid robots draw spotlight at Silicon Valley summit
Humanoid robots took center stage at a major Silicon Valley gathering this week as advances in artificial intelligence renewed investor interest, though doubts remain about how soon humanlike machines will become a practical reality.
More than 2,000 people, including engineers from Disney, Google and dozens of startups, attended the Humanoids Summit to showcase emerging technology and debate how to speed up development of robots designed to move and work like humans. Summit founder Modar Alaoui said many researchers now see humanoids or other physical forms of AI as inevitable, with the main uncertainty being how long it will take.
The recent boom in AI, fueled by systems such as ChatGPT and Google’s Gemini, has injected fresh momentum into a field long considered too complex and expensive for investors. Supporters argue that the same breakthroughs that improved language-based AI are also helping robots better understand their surroundings and perform tasks using vision and language models.
Disney highlighted its progress with a walking robotic version of the “Frozen” character Olaf, which is expected to roam independently in Disneyland parks in Hong Kong and Paris early next year. While such entertainment-focused machines already exist, experts said truly general-purpose robots capable of contributing meaningfully in homes or workplaces are still years away.
Skepticism was evident even among conference participants. Cosima du Pasquier, co-founder of Haptica Robotics, said the humanoid sector still faces major scientific and engineering hurdles, noting that much research remains unresolved.
According to consultancy McKinsey, around 50 companies worldwide have raised at least $100 million to develop humanoid robots, with China leading the race. Government incentives, a push to build a full humanoid ecosystem by 2025 and strong manufacturing capacity have given Chinese firms an edge, reflected in their dominance at the summit’s exhibition area.
In contrast, U.S. efforts have been driven largely by private investment and excitement around AI. High-profile skeptics remain, including robotics pioneer Rodney Brooks, who has argued that current humanoids are unlikely to achieve true dexterity despite massive funding.
Some practical deployments are already under way. Agility Robotics recently announced that its warehouse robot Digit is being tested at a Texas distribution center run by Mercado Libre, showing how robots with limited humanlike features are entering workplaces.
Industry leaders said competition between countries is intensifying. Jeff Burnstein, head of the Association for Advancing Automation, said the United States has strong AI expertise but acknowledged that China currently has greater momentum in humanoid development, leaving the question of global leadership still open.
4 months ago
The bacteria turning plastic waste into painkillers
Earlier this year, scientists reported a breakthrough in biotechnology. A common bacterium was genetically engineered to convert plastic waste into the widely used painkiller paracetamol.
The bacterium, Escherichia coli (E. coli), was modified by Stephen Wallace, professor of chemical biotechnology at the University of Edinburgh, to digest a plastic-derived molecule and transform it into the drug.
While E. coli is often associated with food poisoning, non-pathogenic strains are widely used in laboratories as the field’s main “workhorse.”
Prof Wallace has previously engineered E. coli to turn plastic waste into vanilla flavoring and sewer “fatberg” waste into perfume. “If you want to prove something is possible with biology, E. coli is a natural first stage,” he said.
Beyond laboratories, vats of engineered E. coli serve as living factories, producing vital substances such as insulin, which is essential for diabetes treatment, as well as chemicals for fuels and solvents.
Why E. coli dominates biotechnology
According to Princeton University professor Thomas Silhavy, E. coli’s dominance began with its use as a model organism to understand basic biology. First isolated in 1885 by German pediatrician Theodor Escherich, its rapid growth and ease of handling made it a natural choice for research.
In the 1940s, studies using a harmless E. coli strain revealed that bacteria could exchange genes through a process akin to “bacterial sex,” reshaping the understanding of microbial genetics. Since then, E. coli has been central to major discoveries, from deciphering the genetic code to becoming the first organism genetically engineered with foreign DNA in the 1970s.
The bacterium was also behind a breakthrough in 1978, when synthetic human insulin was first produced using E. coli, eliminating the reliance on animal-derived insulin that sometimes caused allergic reactions. Nearly two decades later, in 1997, E. coli was among the first organisms to have its entire genome sequenced.
E. coli’s strengths
Adam Feist, professor at the University of California, San Diego, highlights the bacterium’s speed, reliability, and versatility. It thrives on a wide variety of substrates, can be frozen and revived easily, and efficiently hosts foreign DNA. “The more I work with other microorganisms, the more I appreciate just how robust E. coli is,” he said.
Cynthia Collins of Ginkgo Bioworks notes that while more organisms are now available for industrial use, E. coli remains cost-effective and adaptable. Even when producing potentially toxic substances, scientists can often engineer tolerance into the bacterium.
Calls for alternatives
Some experts warn that E. coli’s dominance may limit exploration of other promising microbes. Paul Jensen, a microbiologist at the University of Michigan, argues that undiscovered bacteria in landfills or natural environments might naturally perform valuable processes, such as breaking down plastics or even producing new materials like cement or rubber.
One emerging alternative is Vibrio natriegens (V. nat), first isolated in the 1960s but largely overlooked until recently. With a growth rate twice as fast as E. coli and superior ability to absorb foreign DNA, V. nat could offer significant industrial advantages. Cornell University’s Buz Barstow, who is developing tools to engineer it, compares the leap from E. coli to V. nat as “going from a horse to a car.”
His team has launched a company, Forage Evolution, to advance its applications, with ambitions ranging from producing jet fuel from carbon dioxide to extracting rare earth metals. “Simply put, E. coli won’t get us to any of these visions. V. natriegens might,” Dr Barstow said.
Still, experts like Prof Feist caution that V. nat is not yet ready to replace E. coli at scale, as the essential genetic tools and industrial track record are still lacking. “E. coli is a tough thing to replace,” he said.
Source: Agency
8 months ago
OpenAI, Meta update AI chatbots to better handle teen mental health crises
OpenAI and Meta have announced new safeguards on their chatbots to better protect teenagers showing signs of mental distress or asking about suicide.
OpenAI, the maker of ChatGPT, said Tuesday it will roll out parental controls this fall, allowing parents to link accounts, disable features, and receive alerts if their teen shows “acute distress.” The company added that highly sensitive conversations will be redirected to more advanced AI models for improved support.
The move follows a lawsuit filed last week against OpenAI and CEO Sam Altman by the parents of a 16-year-old boy in California who died by suicide, allegedly after ChatGPT guided him. The family’s lawyer dismissed OpenAI’s announcement as “vague promises.”
Meta, parent of Facebook, Instagram and WhatsApp, said its chatbots will no longer discuss self-harm, suicide, eating disorders or inappropriate romantic issues with teens, instead referring them to expert resources.
A recent RAND Corporation study found inconsistent responses from leading AI tools, urging independent safety standards and clinical testing.
8 months ago
SpaceX Starship launches 8 test satellites, splashes down in Indian Ocean
SpaceX successfully conducted the latest test flight of its massive Starship rocket on Tuesday night, marking the first-ever deployment of a test payload — eight dummy satellites — into orbit. After coasting through space for just over an hour, Starship splashed down as planned in the Indian Ocean.
The rocket lifted off from SpaceX’s Starbase in south Texas shortly after 6:30 p.m. This marked the 10th test of the world’s largest and most powerful rocket, which SpaceX and NASA aim to use for future lunar missions.
NASA has contracted two Starships to carry astronauts to the moon later this decade, while SpaceX CEO Elon Musk envisions missions to Mars. No crew members were aboard this demonstration launch.
The test also saw the successful return of Starship’s Super Heavy Booster, which landed in the Gulf of Mexico after executing a landing-burn engine sequence. Meanwhile, the Starship orbited Earth, moving from daylight in Texas through night and back into daytime, before firing its engines to flip upright and enter the water nose-first.
The successful mission follows a year of setbacks. Earlier tests in January and March ended minutes after liftoff, scattering debris into the ocean. The ninth test in May ended when the spacecraft tumbled uncontrollably and broke apart.
SpaceX recently redesigned the Super Heavy booster with larger, stronger fins for improved stability, the company said on X this month. The very first Starship exploded minutes into its 2023 inaugural flight.
SpaceX first launched Starlink satellites in 2019 from a Falcon rocket at Cape Canaveral.
9 months ago
China’s humanoid robots outshine human footballers, draw crowds with AI-driven matches
While China’s national men’s football team continues to disappoint on the international stage, humanoid robots are capturing attention in Beijing — not for their athletic skills, but for the cutting-edge AI technology behind them.
On Saturday night, four teams of humanoid robots competed in fully autonomous 3-on-3 football matches, powered entirely by artificial intelligence. The event, promoted as the first of its kind in China, also served as a preview for the upcoming World Humanoid Robot Games, scheduled to be held in Beijing.
Organizers highlighted that the robots played the matches without any human control, relying solely on AI-based strategies and decision-making.
Outfitted with sophisticated visual sensors, the robots could track the ball and maneuver around the field with surprising agility. They were even programmed to pick themselves up after falling. Still, in a display of realism, some robots had to be carried off on stretchers after toppling over during play.
China launches powerful hydrogen generator to cut emissions
China is ramping up efforts to advance AI-driven humanoid robots, using sports such as marathons, boxing, and football as testing grounds to refine their performance in real-world scenarios.
Cheng Hao, founder and CEO of Booster Robotics—the company that provided the robot players—described sports competitions as ideal environments to develop the complex interaction between hardware, software, and AI algorithms.
Cheng also underlined the importance of safety, especially with future plans for human-robot matches.
“In the future, we might organize football games between robots and humans. For that to happen, we must guarantee absolute safety,” Cheng explained. “These matches wouldn’t focus on winning or losing but would allow for real offensive and defensive interactions. That’s how we can build public trust and show that robots are safe.”
Booster Robotics supplied the hardware for all four university teams, while the universities themselves developed the AI algorithms for perception, game strategy, formations, and passing — considering variables such as speed, force, and direction, according to Cheng.
In the final, Tsinghua University’s THU Robotics defeated the China Agricultural University’s Mountain Sea team with a 5-3 scoreline to claim the championship.
Tsinghua supporter Mr. Wu cheered his team’s victory but also praised the competition.“THU performed really well,” he said. “But the Mountain Sea team from Agricultural University also exceeded expectations. It was a thrilling match.”
China’s men’s football team, meanwhile, has only qualified for the World Cup once and has already been eliminated from next year’s tournament in Canada, Mexico, and the United States.
10 months ago